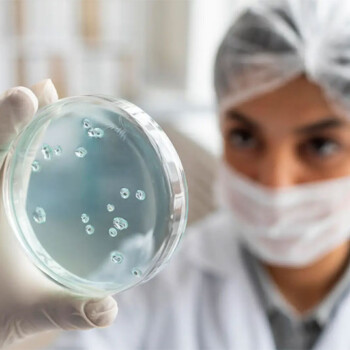

El Ministerio de Salud confirmó el tercer caso de viruela símica en el país en un ciudadano de 36 años residente en la Ciudad de Buenos Aires, el primero sin antecedente de viaje en el país.
El Laboratorio Nacional de Referencia INEI- ANLIS Malbrán confirmó el 9 de junio el primer caso de viruela símica sin antecedentes de viaje en Argentina en un hombre de 36 años residente en CABA que “se encuentra en buen estado de salud, cumpliendo el aislamiento correspondiente e internado para su cuidado”.
La cartera detalló que el paciente realizó la primera consulta el 6 de junio en una clínica privada de la ciudad de Buenos Aires y que inició síntomas el 31 de mayo presentando dolor de cabeza y muscular, fiebre, dolor de espalda.
Además, desarrolló “exantemas vesiculares a partir del 2 de junio. El 7 de ese mes se notificó el caso y la muestra fue derivada al laboratorio ANLIS Malbrán, que el 9 de junio emitió el resultado positivo de la PCR”.
Este es el tercer caso confirmado en el país y los tres pacientes se encuentran en buen estado de salud, sin haber presentado complicaciones, al tiempo que no se detectaron casos secundarios entre los contactos estrechos.
En el mundo se reportaron 1.285 casos al 8 de junio en 28 países en donde la viruela símica no es endémica, sin personas fallecidas
Desde principio de año, en el continente africano, se reportaron 1.536 casos sospechosos (1.356 corresponden a la República Democrática del Congo) y 72 fallecidos.
La viruela símica se transmite de una persona a otra por contacto cercano con lesiones, partículas respiratorias y materiales contaminados, como la ropa de cama.
En los brotes registrados en Europa, la presentación clínica generalmente se describe como leve, y la mayoría de los casos presentan -de la misma manera que los casos detectados hasta ahora en Argentina- lesiones en diferentes partes del cuerpo.
Esto incluye genitales o el área perigenital, lo que indica que la transmisión probablemente ocurra a través del contacto físico durante actividades sexuales.
Los síntomas clásicos son: fiebre, dolor de cabeza, muscular o de espalda, inflamación de ganglios y cansancio.
Entre 1 y 5 días posteriores se agrega erupción en la piel, que pasa por distintos estadios hasta formar una costra que luego se cae. Las personas infectadas contagian hasta que se hayan caído todas las costras.
Los modos de transmisión durante el contacto sexual siguen siendo desconocidos, si bien se sabe que el contacto físico cercano puede conducir a la transmisión, “no está claro qué papel juegan los fluidos corporales sexuales, incluidos el semen y los fluidos vaginales, en la transmisión”, indicó el Ministerio.
Las medidas de prevención incluyen evitar el contacto estrecho con personas que presenten síntomas compatibles, incluyendo el contacto íntimo o sexual con personas durante el periodo de enfermedad.
El Ministerio destacó que “se debe tener en cuenta que el riesgo de transmisión aumenta en actividades sexuales con múltiples personas”.
Por eso quienes hayan participado en este tipo de eventos “deben prestar atención a su estado de salud durante los próximos 21 días y realizar una consulta médica ante la aparición de síntomas compatibles con la enfermedad”.
Fuente: Agencia de Noticias Télam